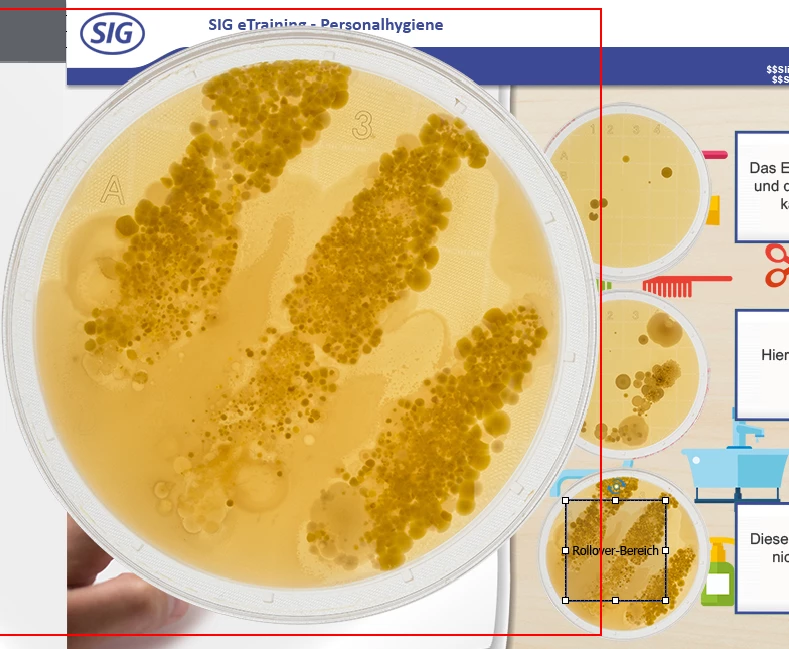

Rollover Picture - Image quality
Hi
I have a problem with the Rollover Image function. In captivate, the resolution of the picture ist good. But when i export the file or use the preview function, the quality of the rollover image ist really bad.
Here in Captivate (2017)
Here in the preview

How can i rech a better resolution? Or know somebody a alternative funktion for rollover images? Now i export and preview with Shockwave. But maybe there is a besser solution that is also compatible with HTML5 for the future?
Thank you.
